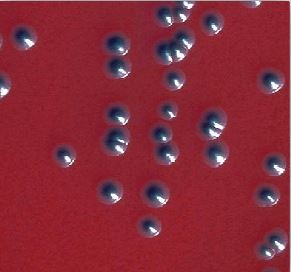
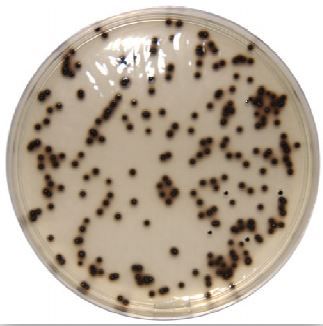

النبات

مواضيع عامة في علم النبات

الجذور - السيقان - الأوراق

النباتات الوعائية واللاوعائية

البذور (مغطاة البذور - عاريات البذور)

الطحالب

النباتات الطبية


الحيوان

مواضيع عامة في علم الحيوان

علم التشريح

التنوع الإحيائي

البايلوجيا الخلوية


الأحياء المجهرية

البكتيريا

الفطريات

الطفيليات

الفايروسات


علم الأمراض

الاورام

الامراض الوراثية

الامراض المناعية

الامراض المدارية

اضطرابات الدورة الدموية

مواضيع عامة في علم الامراض

الحشرات


التقانة الإحيائية

مواضيع عامة في التقانة الإحيائية


التقنية الحيوية المكروبية

التقنية الحيوية والميكروبات

الفعاليات الحيوية

وراثة الاحياء المجهرية

تصنيف الاحياء المجهرية

الاحياء المجهرية في الطبيعة

أيض الاجهاد

التقنية الحيوية والبيئة

التقنية الحيوية والطب

التقنية الحيوية والزراعة

التقنية الحيوية والصناعة

التقنية الحيوية والطاقة

البحار والطحالب الصغيرة

عزل البروتين

هندسة الجينات


التقنية الحياتية النانوية

مفاهيم التقنية الحيوية النانوية

التراكيب النانوية والمجاهر المستخدمة في رؤيتها

تصنيع وتخليق المواد النانوية

تطبيقات التقنية النانوية والحيوية النانوية

الرقائق والمتحسسات الحيوية

المصفوفات المجهرية وحاسوب الدنا

اللقاحات

البيئة والتلوث


علم الأجنة

اعضاء التكاثر وتشكل الاعراس

الاخصاب

التشطر

العصيبة وتشكل الجسيدات

تشكل اللواحق الجنينية

تكون المعيدة وظهور الطبقات الجنينية

مقدمة لعلم الاجنة


الأحياء الجزيئي

مواضيع عامة في الاحياء الجزيئي


علم وظائف الأعضاء


الغدد

مواضيع عامة في الغدد

الغدد الصم و هرموناتها

الجسم تحت السريري

الغدة النخامية

الغدة الكظرية

الغدة التناسلية

الغدة الدرقية والجار الدرقية

الغدة البنكرياسية

الغدة الصنوبرية

مواضيع عامة في علم وظائف الاعضاء

الخلية الحيوانية

الجهاز العصبي

أعضاء الحس

الجهاز العضلي

السوائل الجسمية

الجهاز الدوري والليمف

الجهاز التنفسي

الجهاز الهضمي

الجهاز البولي


المضادات الميكروبية

مواضيع عامة في المضادات الميكروبية

مضادات البكتيريا

مضادات الفطريات

مضادات الطفيليات

مضادات الفايروسات

علم الخلية

الوراثة

الأحياء العامة

المناعة

التحليلات المرضية

الكيمياء الحيوية

مواضيع متنوعة أخرى

الانزيمات
الجنس Corynebacterium diphitheriae
المؤلف:
عبد الرزاق سليمان التومي ، محمد محمد الامام ، عبد الباسط رمضان
المصدر:
اساسيات التشخيص البكتريولوجي المعملي والسريري
الجزء والصفحة:
14-7-2016
5474
Corynebacterium diphitheriae
خلايا هذا النوع البكتيري هوائية وغير هوائية اختيارياً facultative anaerobs ولها القدرة على النمو في درجات حرارة ما بين 40-20 درجة مئوية وتعتبر درجة الحرارة 37 هي المثلى ، وهي موجبة لصبغة جرام وغالباً ما يكون الصبغ غير تساوي وباهت، كما أنها متعددة الأشكال والأطوال فتكون أحياناً عصوية وعلى هيئة مضرب الكرة club shape تتواجد في تجمعات ملتصقة بزوايا مختلفة بما يشبه الحروف الصينية . عند صبغتها بصبغة Neisser تظهر أجسام على الأقطاب (وهي عبارة عن عديد الفوسفات مخزنة في أحد الأقطاب). هناك 4 أنواع حيوية biovars وهم gravis وintermedius و mitis وكذلك belganti . وهذه الأسماء تستعمل لوصف شدة الإصابة ويتواجد هذا النوع البكتيري كفلورا طبيعية للقناة التنفسية العلوية والجلد.

مستعمرات النوع البكتيري C. diphtheria بصبغة جرام
الامراضية :
يسبب هذا النوع البكتيري داء الخناق diphtheria خاصة في الأطفال وتم التعرف على هذا المرض سنة 1826 من قبل الطبيب النفسي Pierre F. Bretonneau حيث سماه في البداية la diphtherriteوهذا الاسم باللغة اللاتينية نسبة للغشاء الذي يظهر في الحلق وفي سنة 1883 عزل العالم Edwin KLebs البكتيريا المسببة لهذا المرض من حلق المريض وفي السنة الموالية استطاع العالم Friederich Loeffler تنمية البكتيريا الممرضة وقام بتسميتها بــ Klebs Loeffler bacillus ثم سميت بالنوع البكتيري الاعراض الرئيسية ظهور وذمة Oedema على الرقبة وتحدث الإصابة نتيجة استنشاق الرذاذ الملوث بالسلالات الممرضة virulent strains والتي تفرز ذيفان خارجي exotoxin يتم امتصاصه من خلال الغشاء المخاطي التألف فيصل إلى مجرى الدم، وإذا لم يثبط مفعوله من خلال antitoxin فإن هذا الذيقان على اللاقمة الفيروسية bacteriophages للسلالة الممرضة من هذا النوع البكتيري. خلال الإصابة سيظهر تهيج حاد في مكان هذه الإصابة مؤدياً لتكون غشاء بلون رمادي ــ أصفر pseudomembrane والذي يتلف (necrosis) في المراحل المتأخرة من الإصابة ، وإذا ما انتشر هذا الغشاء ليصل إلى الحنجرة larynx فمن الممكن سد مجرى الهواء مؤدياً إلى الوفاة نتيجة الاختناق asphexia.

اعراض داء الخناق "تغير لون الغشاء إلى اللون الرمادي" Diphtheria pseudomembrane
أما في حالات الإصابة الجلدية فإن هذا النوع البكتيري يمكن ان يحدث الإصابة من خلال الجروح، من النادر في هذا النوع من الإصابات أن تحدث مضاعفات خطرة. تنتشر هذه الإصابة الجلدية في العديد من الدول النامية وخاصة في المناطق الريفية مما يكسب الأشخاص المصابين مناعة مبكرة للوقاية من النوع البكتيري C. diphtheria الأمر الذي قلل من معدل حدوث الإصابات التنفسية .

صيغة جرام لإفرازات الجروح تظهر وجود مستعمرات النوع البكتيري C. diphtheriae
من المهم جداً المعالجة السريعة للحالات التي يعتقد أنها داء الخناق بإعطائهم مضاد الذيفان antitoxin حيث أن هذا الذيفان مميت وسريع التأثير.
يتكون الذيفان الخارجي من قطعتين (أ) و (ب) fragment A & B ، القطعة ب ترمز للإرتباط بمستقبل الخلية المستهدفة binding to receptors ، أما القطعة (أ) فهي ترمز لنشاطه السمي toxic activity وهي تقوم بمنع تصنيغ البروتين مما يؤدي لموت الخلية (necrosis).
التشخيص المعملي :
للتأكد من تشخيص الحالة المرضية على أنها حالة الخناق يتم تجميع عينة مسحة الحلق و (أو) مسحة البلعوم الأنفي وفي حالات الإصابة الجلدية يتم أخذ مسحة من الجلد.
حبيبات فوليوتن volutin granules :
ــ تظهر اللطاخة المصبوغة Albert srained smears خاصة المأخوذة من Loeffler serum أو من Dorset rgg culture خلايا النوع البكتيري C. diphtheria غالباً ما تكون على هيئة سبحية وذلك لوجود الحبيبات داكنة الصبغ ، وهذه الحبيبات تسمى فوليوتين او حبيبات metachrimatic ، وهي عبارة عن وحدات من عديد الفوسفات غير العضوي المخزن للطاقة عند صبغ اللطاخة بإستعمال التولويدين الأزرق فإن الخلية البكتيرية تظهر بلون أزرق باهت بينما الحبيبات تكون بلون أحمر ــ بنفسجي غامق.

صبغة Loffler methylene blue للنوع البكتيري C. diphtheriae
ــ الوسط الغذائي Loffler serum meduim و Dorest egg medium :
المستعمرات البكتيرية لهذا النوع من البكتيري تنمو بسرعة على هذه الأوساط الغذائية وذلك خلال 6-4 ساعات، وهي تساعد على ظهور الحبيبات وكافة الخصائص الظاهرية ، إلا أنه لا ينصح باستعمالهم كوسط غائي أولي حيث يمكن للعديد من البكتيريا المكونة للفلورا الطبيعية النمو مما يحجب نمو النوع البكتيري C. Diphtheriae .
ــ الوسط الغذائي Tellurite blood agar :
وهو يستعمل كوسط غذائي أولي primary medium لعزل هذا النوع البكتيري من مسحة الحلق ومسحة البلعوم الأنفي حيث يقوم باختزال المادة tellurite منتجة مستعمرات بكتيرية التحضين. السلالة البكتيرية Mitis تظهر إحلال كامل لكريات الدم الحمراء B- haemolysis البكتيرية المكونة للفلورا الطبيعية تنمو على هيئة مستعمرات بكتيرية رمادية دون إحلال لكريات الدم الحمراء وبقطر 0.8 – 0.1 مم، وتكون المستعمرات المنعزلة بلون أقل من المستعمرات النامية في تجمع .
مستعمرات النوع البكتيري C. diphtheria على الوسط الغذائي Blood agar.
ــ الوسط الغذائي Tinsdale medium :
بعد التحضين لمدة 48-24 ساعة يظهر النوع البكتيري C. diphtheria مستعمرات بكتيرية ذات لون رمادي ــ أسود منتفخة ومحاطة بحلقة بنية غامقة ناتجة من تكون كبريتيد الهيدروجين hydrogen sulphide ، وهذ الحلقة هو ما يميزها عن نمو بكتيريا الفلورا الطبيعية للقناة التنفسية.
النوع البكتيري C. diphtheria على Tinsdale medium
الاختبارات المعملية :
ــ اختبار الكشف على إنزيم catalase : موجب.
ــ اختبار الكشف على النترات : موجب .
ــ اختبار الكشف على انزيم oxidase : سالب.
ــ اختبار الكشف على تخمر سكر الجلوكوز وسكر الماتوز مع تكون الغاز : موجب ، كما أن بعض سلالات النوع gravis و mitis لها القدرة على تخمير سكر السكروز.
ــ اختبار تخمير النشأ starch : موجب مع أنتاج الغاز بالنسبة للجنس البكتيري C. diphtheria gravis .
الكشف على النوع البكتيري C. diphtheria المفرز للذيفان :
يتم التعرف على وجود هذا النوع البكتيري المفرز للذيفان بوجود خطوط و أقواس الترسب حيث أن أغلب سلالات النوع الحيوي gravis والنوع الحيوي intermedius حوالي 80 % من سلالات النوع الحيوي mitis لها القدرة على إفراز الذيفان .
 الاكثر قراءة في البكتيريا
الاكثر قراءة في البكتيريا
 اخر الاخبار
اخر الاخبار
اخبار العتبة العباسية المقدسة

الآخبار الصحية















 قسم الشؤون الفكرية يصدر كتاباً يوثق تاريخ السدانة في العتبة العباسية المقدسة
قسم الشؤون الفكرية يصدر كتاباً يوثق تاريخ السدانة في العتبة العباسية المقدسة "المهمة".. إصدار قصصي يوثّق القصص الفائزة في مسابقة فتوى الدفاع المقدسة للقصة القصيرة
"المهمة".. إصدار قصصي يوثّق القصص الفائزة في مسابقة فتوى الدفاع المقدسة للقصة القصيرة (نوافذ).. إصدار أدبي يوثق القصص الفائزة في مسابقة الإمام العسكري (عليه السلام)
(نوافذ).. إصدار أدبي يوثق القصص الفائزة في مسابقة الإمام العسكري (عليه السلام)


















